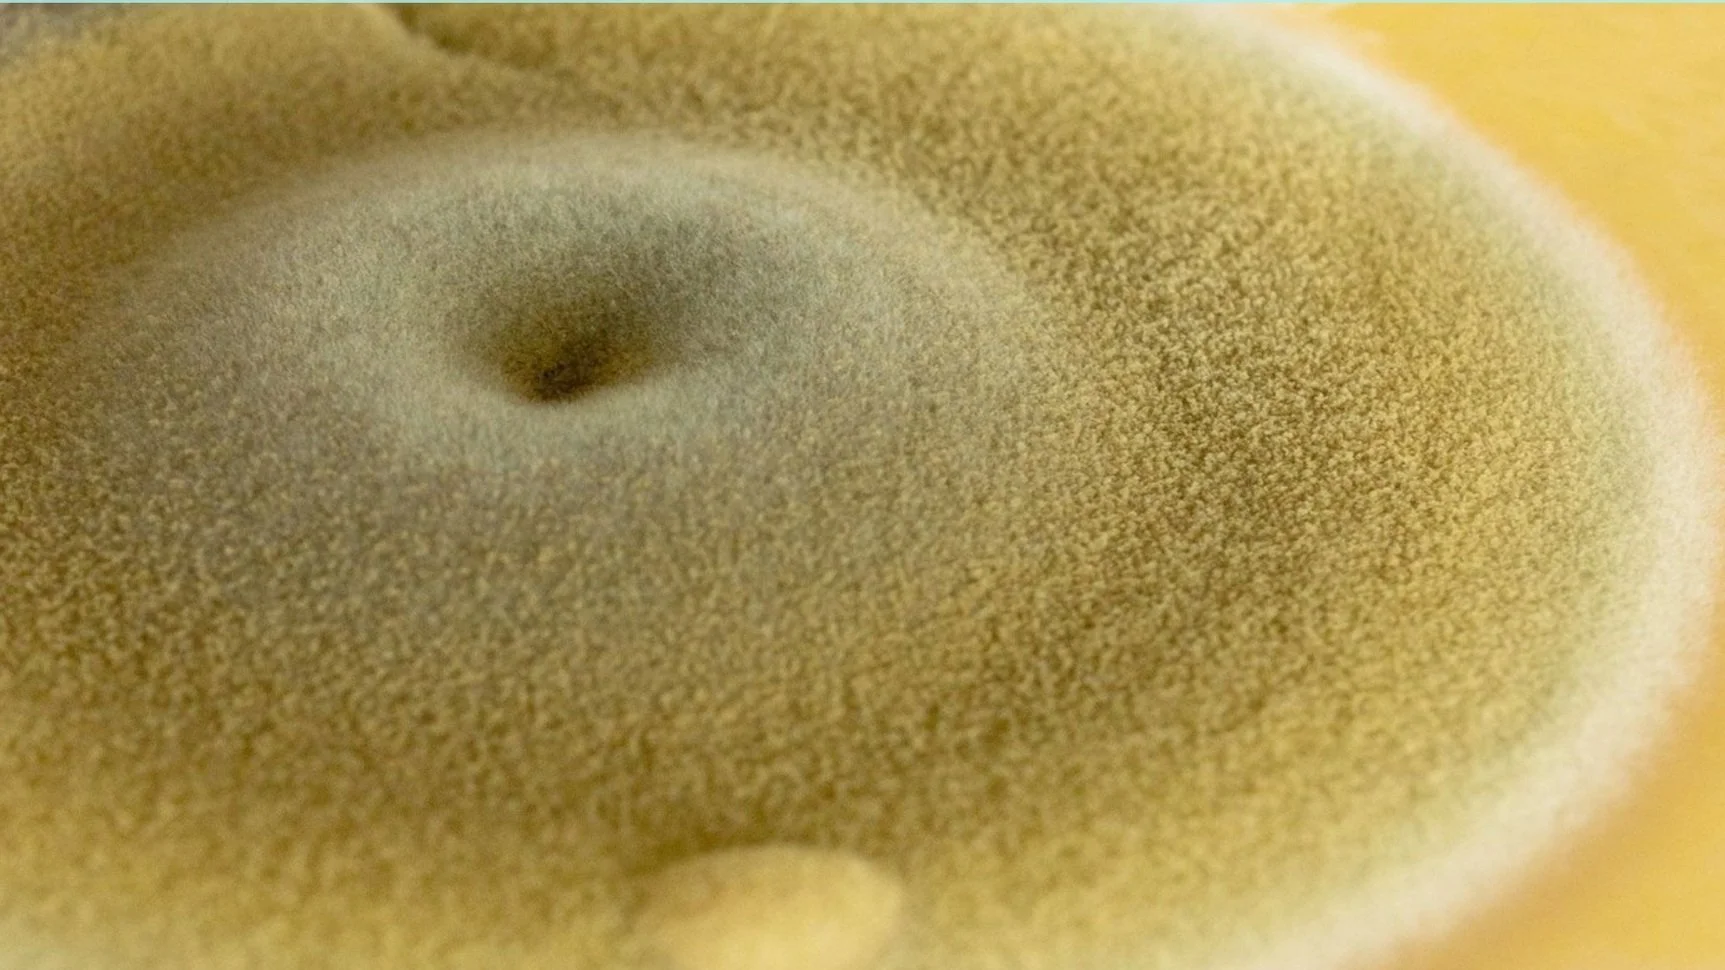

2025 Residencies
Learn more about the artists, researchers and communities in residence at Science Gallery London.
Just Futures
Just Futures is a residency programme for young and emerging creatives, activists or convenors to explore and experiment with ideas for what just futures could look like. We recognise that to create a just world, young people need to be at the centre of shaping and designing structures, systems and ideas for future living.
Making Time
Making Time is a research programme that supports artists to experiment with repositioning the planet as a primary stakeholder in their practice. Without prescribed outcomes, the programme champions new material possibilities, environmental sustainability, and behavioural change in the sector.
Previous Residencies
HEY! SIS.
Hey, Sis. were Science Gallery London’s 2025 Just Futures Residents. Their platform is a place where Gen Z women and girls - from the global majority - can connect, create and thrive free from societal limitations. They used visual and embodied methods to explore the theme of ‘Joy As Resistance’.
THE SPIT GAME UK
Science Gallery London’s first Just Futures residents were The Spit Game UK, a collective of young Black creatives. Over the year, they developed a research-informed approach to their creative practice, broadening the impact of their work and highlighting the urgency of the issues they explore.
STUDIO QUANTUM
Science Gallery London is the UK partner for this international artist-in-residence programme from the Goethe-Institut, which explored important cultural, ethical and ecological questions around the impact of quantum technologies.